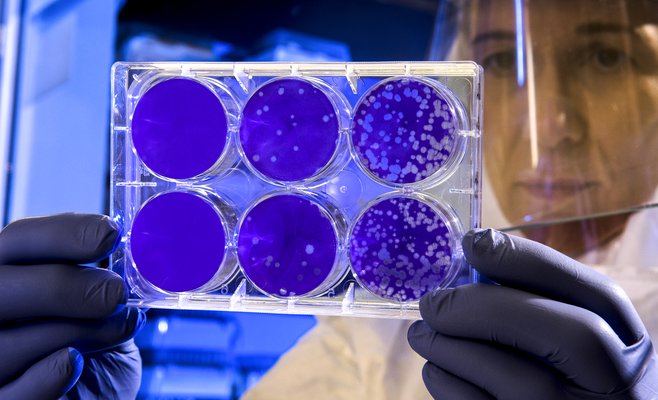
Коронавирус в ЧР бьет рекорды: впервые более 5 тысяч инфицированных, более 200 новых случаев

Популярное
На Чехию обрушился сильный ветер, порывы которого достигают 130 км/ч в низинах и 180 км/ч в горах. Из-за поваленных деревьев частично остановлено движение транспорта не только во многих чешских городах, но и на крупных автомагистралях. К сожалению, непогода нанесла не только материальный ущерб, но и не унесла жизни двух человек.
В Йичине погиб местный житель, на него упало дерево, когда он шёл по тротуару. В Тршебиче скончалась женщина, после того как на неё обвалилось дерево в городском парке.
Around Prague следит за актуальной ситуацией в Чехии в этом материале.

.jpg)

-covid-19-test-in-gaeta-italy-may-6-2020-200506-n-rg482-00.jpg)




.jpg)
